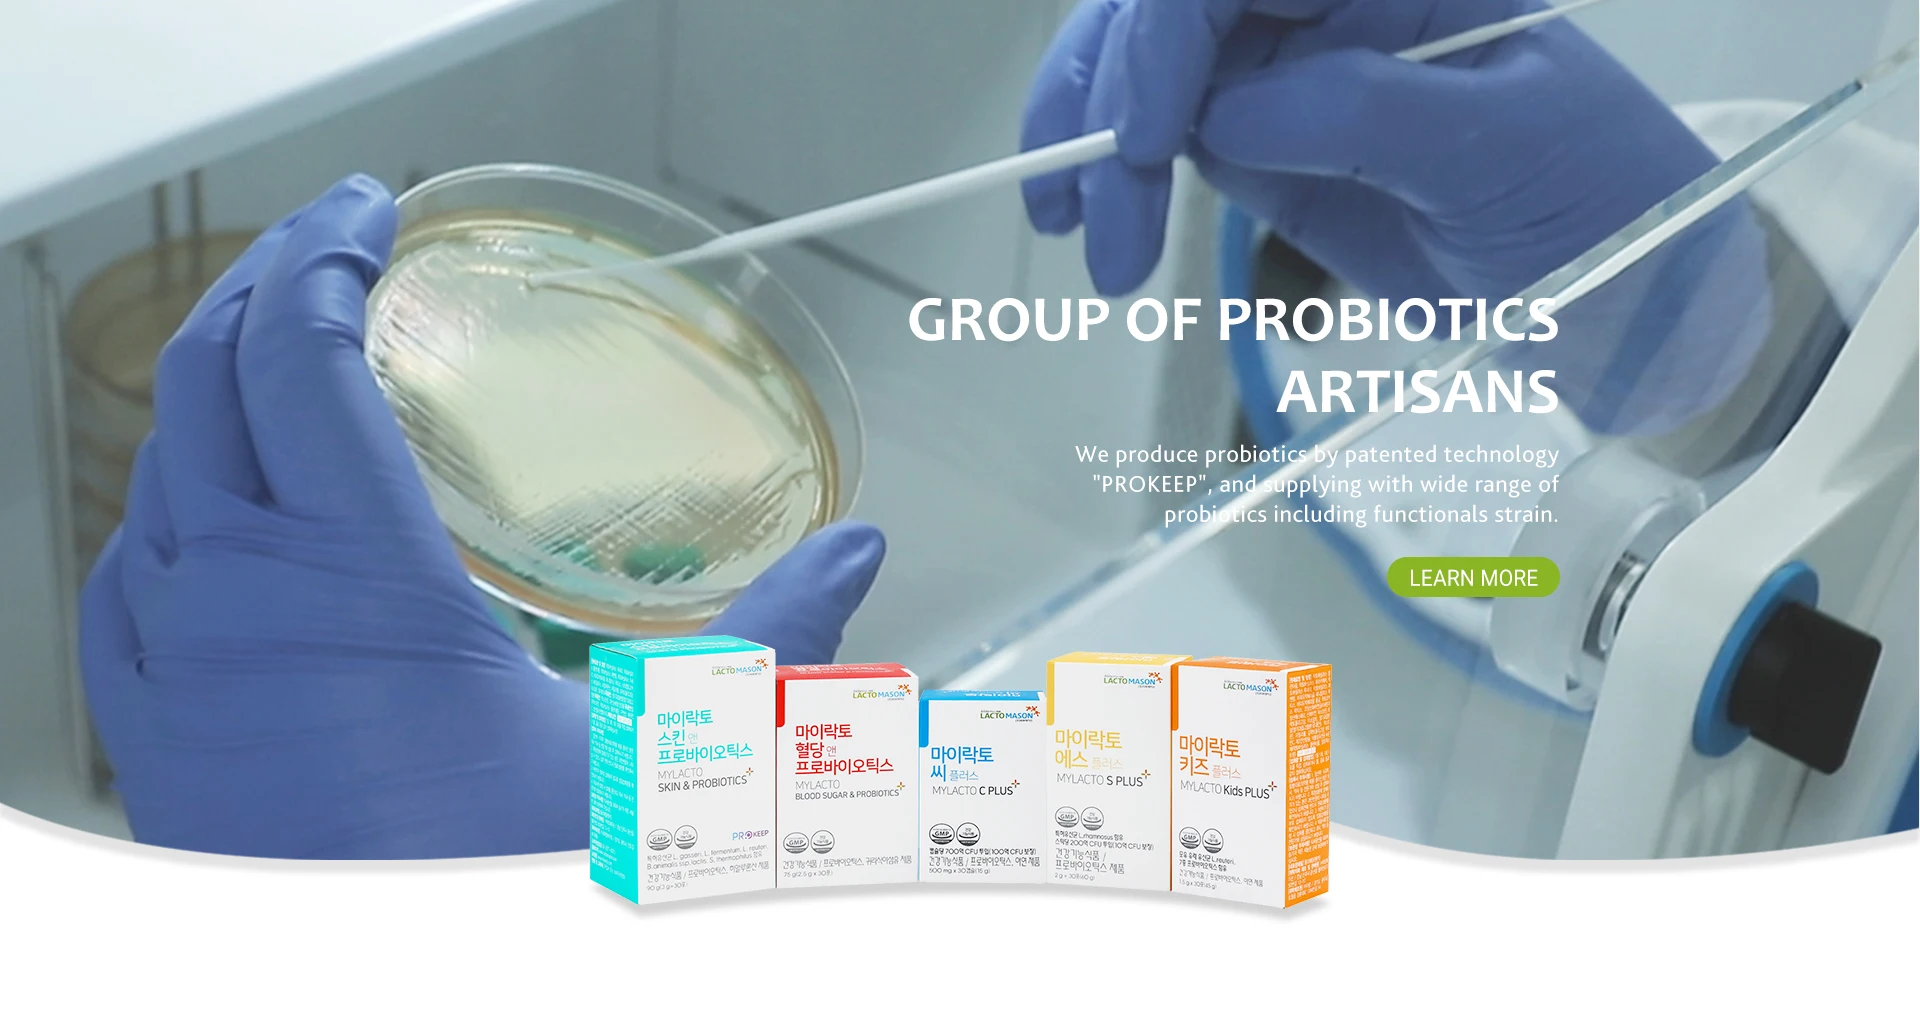

Blood sugar control sachet probiotic powder korean supplement
- Category: >>>
- Supplier: LACTOMASON CO. LTD
Share on (1600190834616):
Product Overview
Description
Products Description

(Blood Sugar Probiotics) MyLacto Blood Sugar & Probiotics, Probiotics for inhibition blood sugar
Brand Name | MYLACTO |
Place of Origin | Rep. of Korea |
Type | Health Supplement |
Processing Time | 15 days after payment deposit is confirmed. |
Supply Ability | 60,000 EA /month |
Advantage | Best quality / Patent strains |
Main market | All around the world |
HS code | 2106.90 |
Company Profile

LactoMason is a group of probiotics artisans. We produce probiotics by patented technology "PROKEEP", and supplying with wide range of probiotics including functionals strain. We also have developed new heat-treated probiotics, called PROMUNE, which have superior immune activity compared to existing Live Probiotics and other heat-treated Probiotics.
We also develop probiotics OEM product with various concept such as immunity, skin care, diet, anti-obesity etc.
We also develop probiotics OEM product with various concept such as immunity, skin care, diet, anti-obesity etc.
We Recommend
New Arrivals
New products from manufacturers at wholesale prices